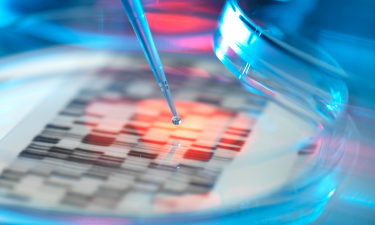
identification-screening-antibodies

The Biology Solution for Biologics Discovery
The Dotmatics Biology Solution supports drug discovery across a wide range of biologic therapeutics including antibodies, CAR-T cells, and RNA therapeutics.
The solution provides end-to-end biologics data management and analysis capabilities that fit into established complex workflows, while the platform enables structured data for users to easily access, collaborate, visualize, and analyze results.
Explore the Dotmatics Difference
Identification, Screening, and Selection of Antibodies
Explore how three scientists created a collaborative, automated, and simplified workflow to expedite the antibody selection process.

The Pursuit of Follow-on Biologics, Biosimilars, and Biobetters
Data is the key and dotmatics can provide a united scientific research informatics platform that allows organizations to make the most of their time and data.

Barriers to Innovation in Biologics
With pressures mounting, biologics innovators must work both smarter and faster, beginning in the earliest days of discovery.
Discover the Biology Solution
Capabilities | Platform Scope | Benefits |
|---|---|---|
Molecular Cloning and Vector Design | Design vectors in SnapGene or Geneious Prime and capture experimental details in a biology ELN experiment | Vector designs are associated with experimental results, so you’ll always know what’s in the tube |
Protein Production | Track the production workflow and produce common biologics in an “paper on glass” ELN | Vectors, expression conditions, purification protocols and final batches are all tracked so that you can find all elements of the process in a single search |
Biologics Registration | Register from the ELN, scientific software like SnapGene and Geneious Prime, or directly in the registration system and track the location of samples in inventory | Reduce rework by tracking what you’ve already made |
Assays | Streamline assay data analysis, standardize for high-throughput assays, and make sure all assay data is available to everyone on the team | Spend less time on data analysis and more time in the lab |
Results Analysis | Search all your data from one place, collate results from multiple assays, and send results to specialized analysis tools like Prism and Geneious Biologics | Make decisions using ALL of your data |
Scientists Choose Dotmatics

Flexibility & Easy Data Access
Centralized Platform
Efficiency & Productivity
Scalability
Scientists are often forced to compromise either speed or accuracy due to disconnected workflows that result in manual data handling. The Dotmatics integrated platform enables users to visualize and qualify data, to improve data driven decisions.

Access your data: leverage an open file format that ensures data can be integrated across your entire informatics platform.
Visualize your data: capture advanced visualization capabilities so users can filter data to make better decisions
Efficient data collection: users can stream and parse raw data directly from instruments, which means no more wasted time manually moving, organizing, and converting files.
Enables FAIR data practices: we adhere to FAIR data principles and afford the highest quality standards to ensure quality, accuracy, and traceability of your data.
Eliminate “dark data” caused by manual data handling. The Dotmatics platform manages workflows, applications, instruments, and external resources, ensuring that the user can capture, access, and understand all available data within their ecosystem.
R&D Digital Transformation at Cancer Research UK
“The improved efficiency and availability of data will ultimately improve experimental turnaround and throughput.”
Daniel James
Cancer Research UK, Beatson
Barriers to Innovation in Biologics
With pressures mounting, biologics innovators must work both smarter and faster, beginning in the earliest days of discovery.
Download Ebook
Blogs
Content
Webinars
Press Releases
Ready to transform to data-driven decision making?
Get in touch so we can provide you with a demo based on your specific needs.


